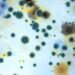
Top 5 Common Myths About Mold Debunked: Unveiling Scientific Truth
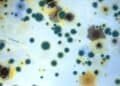
Top 5 Common Myths About Mold Debunked: Unveiling Scientific Truth

Asbestos is a naturally occurring mineral that was widely used in the construction industry due to its heat-resistant properties and durability. However, it was later discovered that asbestos exposure can lead to serious health risks, including lung cancer, mesothelioma, and asbestosis. Despite the known health risks, asbestos was used extensively in construction projects throughout the 20th century, leading to widespread environmental contamination.

The long-term effects of asbestos contamination are a growing concern for public health officials and environmental advocates. Asbestos fibers can become airborne and travel long distances, settling on surfaces and contaminating soil, water, and vegetation. The environmental presence of asbestos can lead to ongoing exposure for nearby communities, even after the source of contamination has been removed.
Examining the long-term effects of asbestos contamination is essential for understanding the ongoing risks to public health and the environment. By exploring the historical context of asbestos use, the health effects of exposure, and methods of detection and analysis, we can gain a more comprehensive understanding of the environmental impact of asbestos contamination.
Key Takeaways
- Asbestos was widely used in construction throughout the 20th century, leading to widespread environmental contamination.
- Asbestos fibers can become airborne and travel long distances, contaminating soil, water, and vegetation.
- Examining the long-term effects of asbestos contamination is essential for understanding the ongoing risks to public health and the environment.
Historical Context of Asbestos Use

Asbestos, a naturally occurring mineral, has been used for centuries due to its unique physical-chemical properties. The mineral has been used in various industries for its heat and fire-resistant properties. However, the use of asbestos has been linked to several health hazards, including lung cancer, mesothelioma, and asbestosis [1].
Asbestos Mining and Industrial Applications
The mining of asbestos began in the 19th century, and its use became widespread in the 20th century. The mineral was used in various industrial applications, including construction materials, insulation, and automotive parts. The use of asbestos peaked in the 1970s, with over 30 million tons being used globally [2].
Asbestos is classified into two main types: serpentine and amphibole. Chrysotile, a serpentine type, was the most commonly used asbestos in industrial applications due to its flexibility and heat-resistant properties. Amphibole asbestos, including crocidolite, was used less frequently due to its brittle nature, but it was still used in some industries.
Regulatory History and Bans
The health hazards associated with asbestos exposure were first recognized in the early 20th century. However, it wasn’t until the 1970s that regulations were put in place to limit its use. In 1971, the US Occupational Safety and Health Administration (OSHA) set limits on the amount of asbestos exposure allowed in the workplace. In 1989, the US Environmental Protection Agency (EPA) issued a ban on most asbestos-containing products [3].
Several other countries, including Canada, have also banned or restricted the use of asbestos. However, asbestos is still used in some countries, particularly in developing nations. The disposal of asbestos-containing waste is also a concern, as improper disposal can lead to long-term environmental contamination [4].
In conclusion, the historical context of asbestos use highlights the widespread use of the mineral in various industries and the associated health hazards. Regulatory measures have been put in place to limit its use, but concerns remain regarding its environmental impact and safe disposal.
[1] “Asbestos Exposure and Cancer Risk,” National Cancer Institute, accessed February 29, 2024, https://www.cancer.gov/about-cancer/causes-prevention/risk/substances/asbestos/asbestos-fact-sheet.
[2] “Asbestos,” World Health Organization, accessed February 29, 2024, https://www.who.int/news-room/fact-sheets/detail/asbestos.
[3] “Asbestos Laws and Regulations,” US Environmental Protection Agency, accessed February 29, 2024, https://www.epa.gov/asbestos/asbestos-laws-and-regulations.
[4] “Asbestos: mining exposure, health effects and policy implications,” PubMed Central, accessed February 29, 2024, https://www.ncbi.nlm.nih.gov/pmc/articles/PMC2323486/.
Properties and Types of Asbestos

Physical and Chemical Characteristics
Asbestos is a naturally occurring mineral that is composed of thin, long fibres. It is known for its heat-resistant properties and has been used in a variety of products such as insulation, roofing, and flooring. Asbestos fibres are resistant to heat, fire, and chemicals, which makes them ideal for use in construction materials.
Asbestos fibres are very small and can easily become airborne when disturbed. When inhaled, these fibres can cause serious health problems such as lung cancer, mesothelioma, and asbestosis. Asbestos fibres are not visible to the naked eye and can remain in the air for long periods of time, making them difficult to detect.
Varieties of Asbestos Minerals
There are six different types of asbestos minerals, each with its own unique properties. The three most common types of asbestos are chrysotile, amosite, and crocidolite. Chrysotile is a serpentine mineral, while amosite and crocidolite are amphibole minerals.
Chrysotile is the most commonly used type of asbestos and accounts for approximately 95% of all asbestos used worldwide. It is a serpentine mineral that is composed of curly, flexible fibres. Chrysotile fibres are not as durable as other types of asbestos fibres and are more easily broken down by the body.
Amosite, also known as brown asbestos, is an amphibole mineral that is composed of straight, needle-like fibres. Amosite fibres are more durable than chrysotile fibres and are more likely to remain in the lungs when inhaled.
Crocidolite, also known as blue asbestos, is an amphibole mineral that is composed of straight, needle-like fibres. Crocidolite fibres are the most durable of all asbestos fibres and are more likely to cause health problems when inhaled.
The other three types of asbestos minerals are anthophyllite, tremolite, and actinolite. These minerals are not commonly used in commercial products and are typically found in natural deposits. Anthophyllite, tremolite, and actinolite are all amphibole minerals and are considered to be more hazardous than chrysotile asbestos.
Overall, the properties and types of asbestos minerals are important to understand in order to assess the risks associated with exposure to asbestos. It is important to take precautions when working with asbestos-containing materials to minimize the risk of exposure.
Health Effects of Asbestos Exposure

Asbestos exposure has been linked to a number of health effects, including various types of cancer and non-cancerous conditions. The severity of these health effects depends on the duration and intensity of the exposure, as well as the type of asbestos fibers that were inhaled or ingested.
Asbestos-Related Diseases
Asbestos exposure can lead to a range of asbestos-related diseases, which can take years or even decades to develop. These diseases include mesothelioma, lung cancer, and asbestosis.
Mesothelioma is a rare and aggressive cancer that affects the lining of the lungs, abdomen, or heart. It is almost exclusively caused by exposure to asbestos fibers. Peritoneal mesothelioma, which affects the lining of the abdomen, is also linked to asbestos exposure.
Asbestosis is a chronic and progressive lung disease that is caused by the inhalation of asbestos fibers. It can lead to scarring of the lungs and difficulty breathing. Pleural plaques, which are areas of thickened tissue on the lining of the lungs, are also a common non-cancerous condition associated with asbestos exposure.
Cancer and Asbestos
Asbestos exposure has been linked to several types of cancer, including lung cancer, stomach cancer, and colorectal cancer. In fact, it is thought that most cases of mesothelioma and lung cancer are due to asbestos exposure.
Smoking tobacco combined with asbestos exposure greatly increases the chance of developing lung cancer. According to the National Cancer Institute, “asbestos workers who also smoke have a risk of developing lung cancer that is greater than the individual risks from asbestos exposure and smoking added together.
Non-Cancerous Asbestos Conditions
In addition to the asbestos-related diseases mentioned above, asbestos exposure can also cause non-cancerous conditions such as pleural effusions (a buildup of fluid between the lung and chest wall), pleuritis (inflammation of the lining of the lungs), and atelectasis (collapse of part or all of a lung).
It is important to note that not everyone who is exposed to asbestos will develop an asbestos-related disease. However, the risk of developing such a disease increases with the duration and intensity of the exposure.
Environmental Presence and Contamination

Asbestos is a naturally occurring mineral that is found in rocks and soil. Its presence in the environment is a result of both natural and human activities. While asbestos is not harmful when it is in its natural state, it becomes a serious health hazard when it is disturbed and released into the air.
Natural Occurrence in the Environment
Asbestos occurs naturally in the environment, and it is found in rocks and soil in many parts of the world. The mineral is made up of tiny fibers that can easily become airborne when the rocks and soil are disturbed. Asbestos fibers are resistant to heat, fire, and chemicals, which made it a popular material for use in construction and manufacturing. However, prolonged exposure to these fibers can lead to serious health problems, including lung cancer, mesothelioma, and asbestosis.
Asbestos in Soil and Water
Asbestos contamination in soil and water is a significant environmental health concern. When asbestos fibers are released into the air, they can settle on the ground and contaminate the soil. Asbestos can also enter the water supply through natural erosion of rocks and soil, as well as through industrial processes.
Contaminated soil and water can pose a serious risk to human health. When asbestos fibers are inhaled or ingested, they can become lodged in the lungs or digestive system, leading to serious health problems. In addition to the health risks posed by asbestos contamination, it can also have a significant impact on water quality and the environment as a whole.
Overall, it is important to understand the risks associated with asbestos contamination in soil and water, and to take steps to prevent exposure. Regular testing of soil and water can help identify areas that may be contaminated, and proper disposal of asbestos-containing materials can help prevent further contamination.
Occupational Exposure and Safety Measures

Asbestos is a hazardous material that poses a significant risk to human health. Exposure to asbestos fibers can lead to a range of serious and potentially fatal diseases, including mesothelioma, lung cancer, and asbestosis. Asbestos was widely used in the construction industry, shipbuilding, and other high-risk industries until the 1980s when its dangers were discovered. Despite the ban on the use of asbestos in many countries, there are still many buildings and products that contain asbestos, posing a risk to workers and the public.
High-Risk Industries and Occupations
Workers in certain industries and occupations are at a higher risk of exposure to asbestos. These include shipbuilding, construction, mining, and manufacturing. Shipbuilding is one of the most high-risk industries for asbestos exposure. The use of asbestos in ships was widespread, and workers who installed or repaired insulation, gaskets, and other materials were often exposed to high levels of asbestos fibers. Construction workers are also at risk, especially those who work in older buildings that contain asbestos insulation, roofing, or flooring. Miners and manufacturing workers who handle asbestos-containing materials are also at risk.
Regulations and Protective Legislation
Occupational health and safety regulations are in place to protect workers from exposure to asbestos. In the United States, the Occupational Safety and Health Administration (OSHA) has established regulations that require employers to protect workers from asbestos exposure. These regulations include requirements for employers to provide protective equipment, such as respirators and protective clothing, and to train workers on the risks of asbestos exposure. In addition, the Environmental Protection Agency (EPA) has established regulations for the handling and disposal of asbestos-containing materials.
Protective legislation has also been put in place to compensate workers who have been exposed to asbestos and developed related diseases. In the United States, the Asbestos Hazard Emergency Response Act (AHERA) requires schools to inspect for asbestos-containing materials and to take steps to remove or encapsulate the materials to prevent exposure. The Asbestos School Hazard Abatement Reauthorization Act (ASHARA) provides funding to schools for asbestos abatement projects.
Overall, it is important for employers to take steps to protect workers from exposure to asbestos. This includes identifying asbestos-containing materials in the workplace, providing protective equipment and training, and following regulations and guidelines for handling and disposing of asbestos-containing materials.
Methods of Asbestos Detection and Analysis

Asbestos is a mineral that is commonly found in building materials, insulation, and other products. Exposure to asbestos can lead to serious health problems, including lung cancer and mesothelioma. As a result, it is important to monitor and test for asbestos in the environment.
Air and Water Quality Monitoring
Air and water quality monitoring are two methods used to detect asbestos in the environment. Air monitoring involves collecting samples of the air and testing them for the presence of asbestos. Water quality monitoring involves collecting samples of water and testing them for the presence of asbestos. Both methods are important for assessing the environmental impact of asbestos contamination.
According to a review article by ScienceDirect, the Yamate method is used to measure the mass asbestos concentration in air. On the other hand, drinking water is analyzed using Methods 100.1 and 100.2 (EPA). The same source also suggests that the analysis of microvac dust samples for asbestos is done using ASTM D 5755-03, while asbestos analysis of settled dust is done through ASTM D 6480-05.
Material Testing and Identification
Material testing and identification is another method used to detect asbestos in the environment. This method involves collecting samples of materials suspected of containing asbestos and testing them for the presence of asbestos. Material testing and identification is important for assessing the risk of asbestos exposure in buildings and other structures.
The National Center for Biotechnology Information provides a comprehensive list of analytical methods for detecting, measuring, and monitoring asbestos. These methods include transmission electron microscopy, scanning electron microscopy, and polarized light microscopy. The same source also states that the intent of the chapter is to identify well-established methods that are used as the standard methods of analysis.
In conclusion, the detection and analysis of asbestos is crucial for assessing the environmental impact of asbestos contamination. Air and water quality monitoring, as well as material testing and identification, are important methods for detecting asbestos in the environment. It is important to use well-established methods of analysis to ensure accurate results.
Remediation and Management of Asbestos

Asbestos Abatement Strategies
Asbestos is a hazardous material that poses a significant threat to the environment and human health. Therefore, it is essential to have effective asbestos abatement strategies in place to minimize the risks associated with asbestos-containing materials (ACMs). The U.S. Environmental Protection Agency (EPA) recommends several strategies for managing asbestos, including encapsulation, enclosure, and removal.
Encapsulation involves applying a sealant to ACMs to prevent the release of asbestos fibers into the air. Enclosure involves constructing a barrier around the ACMs to prevent the release of asbestos fibers. Removal is the most effective strategy for managing asbestos, but it is also the most expensive and disruptive.
Waste Disposal and Containment
Proper waste disposal and containment are critical for managing asbestos-containing waste materials (ACWMs) effectively. The EPA regulates the disposal of ACWMs to ensure that they do not contaminate the environment. ACWMs must be disposed of in a landfill that is specifically designed to handle hazardous waste.
The EPA also recommends that ACWMs be double-bagged in plastic and labeled as hazardous waste. In addition, workers who handle ACWMs must wear protective clothing and equipment to prevent exposure to asbestos fibers.
Overall, effective management of asbestos requires a combination of policies, regulations, and strategies to ensure clean air and a safe environment for all.
Future Outlook and Ongoing Research
Asbestos contamination is a significant environmental issue that poses a long-term threat to human health. Despite the ban on asbestos use in many countries, it remains a persistent problem globally. The World Health Organization (WHO) estimates that asbestos exposure leads to over 100,000 deaths annually worldwide.
There is ongoing research aimed at developing more effective treatments for asbestos-related illnesses. Early diagnosis is crucial in increasing the chances of successful treatment. The National Institute for Occupational Safety and Health (NIOSH) recommends that individuals with a history of asbestos exposure undergo regular medical checkups to detect any signs of asbestos-related diseases.
Research is also focused on identifying new methods of detecting asbestos in the environment. This includes the development of sensors capable of detecting asbestos fibers in the air and water. The use of drones to survey contaminated sites is also being explored.
The WHO has been actively involved in the global effort to eliminate asbestos-related diseases. In 2006, the organization launched the Global Asbestos Initiative, aimed at promoting the safe use of asbestos and the elimination of asbestos-related diseases. The initiative has been successful in raising awareness of the dangers of asbestos and promoting the adoption of safer alternatives.
Despite these efforts, the long-term impact of asbestos contamination on the environment and human health remains a significant concern. Ongoing research and collaboration between government agencies, research institutions, and industry stakeholders are crucial in addressing this issue and minimizing the risks associated with asbestos exposure.
Frequently Asked Questions
What are the potential environmental consequences of improper asbestos disposal?
Improper asbestos disposal can have serious environmental consequences. Asbestos fibers can be released into the air during demolition or renovation of buildings, causing air pollution. These fibers can also contaminate soil and water, leading to further environmental damage. Improper disposal of asbestos-containing materials can also harm human health, as the fibers can be inhaled and cause serious respiratory problems.
How does asbestos contamination affect ecosystems and wildlife?
Asbestos contamination can have a significant impact on ecosystems and wildlife. Asbestos fibers can accumulate in soil and water, potentially contaminating plants and animals. Exposure to asbestos can cause a range of health problems in animals, including respiratory problems, cancer, and other illnesses. Asbestos contamination can also disrupt ecosystems, potentially leading to changes in plant and animal populations.
Can asbestos fibers break down naturally in the environment, and if so, over what time span?
Asbestos fibers do not break down naturally in the environment. Once released into the environment, asbestos fibers can remain in the air, soil, or water for long periods of time. The lifespan of asbestos fibers in the environment can vary depending on a number of factors, including the type of asbestos, the location of the contamination, and the weather conditions in the area.
What are the recommended practices for mitigating asbestos pollution in the environment?
The recommended practices for mitigating asbestos pollution in the environment include proper disposal of asbestos-containing materials, careful monitoring of demolition and renovation activities, and regular testing of soil and water in areas where asbestos contamination is suspected. In addition, it is important to follow all relevant regulations and guidelines related to asbestos disposal and cleanup.
In what ways does naturally occurring asbestos pose risks to the environment?
Naturally occurring asbestos can pose risks to the environment in a number of ways. Asbestos fibers can be released into the air and soil during natural weathering processes, potentially contaminating nearby plants and animals. In addition, mining activities can release large amounts of asbestos fibers into the environment, leading to further environmental damage.
How have regulations and policies evolved to address the environmental impact of asbestos?
Regulations and policies related to asbestos have evolved over time in response to growing concerns about the environmental and health impacts of asbestos exposure. In the United States, the Environmental Protection Agency (EPA) has established a number of regulations related to asbestos disposal and cleanup. In addition, many states and local governments have established their own regulations and guidelines related to asbestos. These regulations and guidelines are designed to protect human health and the environment from the harmful effects of asbestos exposure.